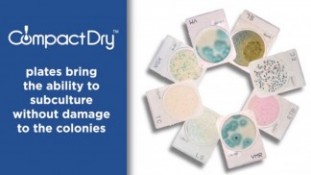
Compact Dry info show.jpg
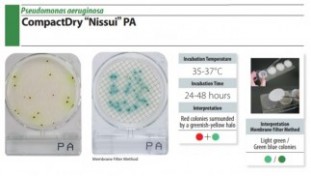
Cd PA.jpg

Compact Worth Corp.
บริษัท คอมแพทค์ เวิร์ธ คอร์ปอเรต จำกัด เป็นผู้จัดจำหน่ายสินค้าเครื่องมือทางห้องปฏิบัติการ เครื่องตรวจวัดและชุดสอบทางวิทยาศาสตร์ในสาขาต่างๆ โดยเฉพาะในด้านเกษตรอาหารและสิ่งแวดล้อม จากโรงงานผู้ผลิตชั้นนำทั่วโลก ด้วยประสบการณ์ดำเนินการนานกว่า10ปี เพื่อสนับสนุนการปฏิบัตงานดำเนินการของท่านให้สำเร็จลุล่วงไปเป็นอย่างดี Compact Worth Corporate Co., Ltd. is a distributor of laboratory equipment, scientific instruments and test kits in various fields especially in agriculture, food and the environment from world-class manufacturers, with more than 10 years of operating experience. We need to support the implementation of your operations to be successful as well.